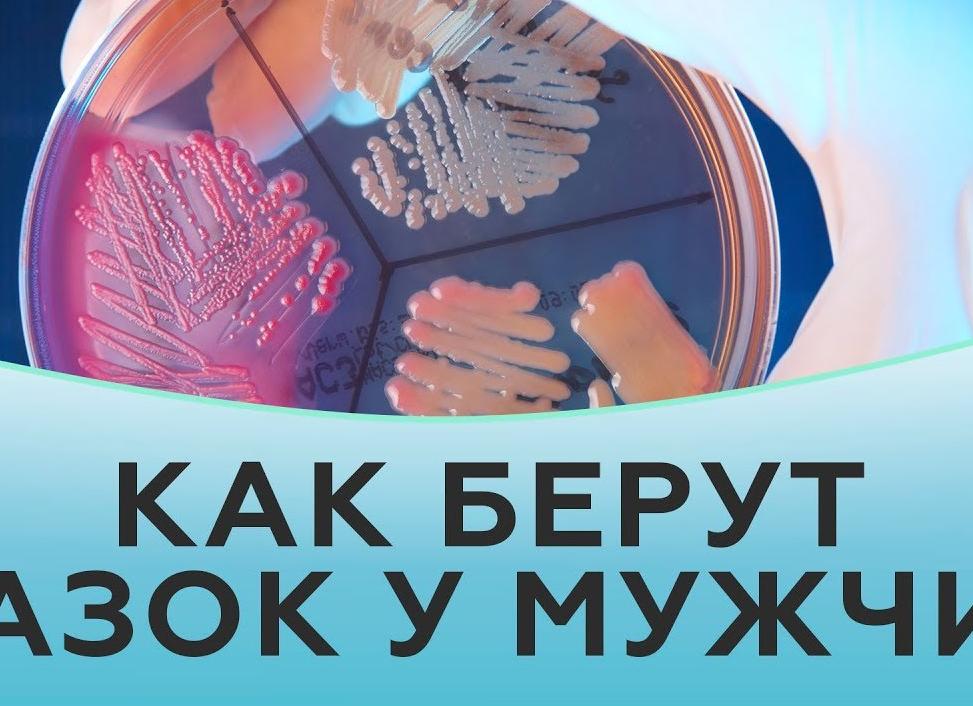
Больно ли брать мазок у мужчин

[Больно ли брать мазок у мужчин]
[Больно ли брать мазок у мужчин]
Больно ли брать мазок у мужчин: как проходит процедура, когда назначают
Одним из методов современной лабораторной диагностики является взятие мазка.
Такую процедуру проводят мужчинам, чтобы установить наличие воспалительных процессов непосредственно в мочеиспускательном канале.
Следовательно, мазок на флору определяет, каков состав микрофлоры и уровень ее патогенности. По результатам такого обследования идентифицируют микроорганизмы, которые провоцируют возникновение инфекций.
Особенности процедуры
Чтобы результат мазка был правильным, мужчине нужно подготовиться к этой процедуре. Вообще взятие мазка порой пугает представителей сильного пола. Они полагают, что такая процедура крайне болезненна.
В действительности если воспалительный процесс присутствует в уретре, то мазок доставит боль. Но болезненность такой процедуры зависит от навыков соответственного специалиста.
Если не соблюдать условий подготовки к мазку, то возможны недостоверные показатели этой манипуляции.
Первым делом мужчине нужно на два дня отказаться от половых контактов. Гигиенические процедуры следует провести в вечернее время, накануне сдачи анализа. С утра гигиена полового органа не нужна. За два часа до сдачи мазка нельзя мочиться.
За четырнадцать суток до процедуры нужно прекратить прием любых медикаментов. Если необходимо применять некоторые препараты на постоянной основе, то этот нюанс нужно обсудить с врачом.
Возможно, специалист назначит временный аналог, не воздействующий на результаты мазка.
Процедуру проводят следующим образом. В мочеиспускательный канал вводят стерильный двухсантиметровый тампон, закрепленный на тонком аппликаторе. Затем его прижимают к стенке канала, вращают, медленно вытаскивают. В некоторых случаях применяют бактериологическую петлю или ложку Фолькмана. Для исследовательских целей используют собранные эпителиальные клетки.
После процедуры, как правило, мужчина ощущает дискомфорт. При сильном воспалении иногда наблюдаются кровянистые выделения. Если после трех дней они не проходят, то следует посетить уролога. Такое явление не свидетельствует о норме.
Следует понимать, что достоверность результатов во многом зависит от правильной подготовки к процедуре. Поэтому важно ответственно к ней отнестись. Это поможет избежать необходимости повторного взятия мазка.
Необходимость процедуры
В настоящее время в урологии применяют множество видов диагностики. Но одной из самых легкодоступных и недорогих форм анализа признан именно мазок из уретры.
Суть процедуры состоит в лабораторном изучении тканей, взятых из мочеиспускательного канала. Мазок — это ценное диагностическое мероприятие, которое позволяет быстро выявить, проанализировать ряд недугов.
С помощью такого материала специалисты проверяют состав, а также качество микрофлоры в уретре.
Большинство врачей нынче сходится во мнении, что такой анализ попросту незаменим. Он позволяет определить наличие, количество, разновидность микроорганизмов в мужской уретре. Взятие мазка позволяет выяснить в кратчайшие сроки, что предстоит лечить. В итоге это позволяет своевременно подобрать оптимальную терапевтическую схему.
В мужском организме нередко присутствуют скрытые инфекции. Их сложно определить через анализ крови или другие распространенные методики исследования.
Нередко мужчины даже не догадываются, какие симптомы могут быть при определенных недугах. В итоге они обращаются в медучреждение лишь при сильном обострении проблемы.
Поэтому современные урологи все чаще проверяют мужчин с помощью мазка из уретры, чтобы выявить скрытые инфекции.
Своевременное определение вредных микроорганизмов способствует предотвращению их последующего развития. Это позволяет нейтрализовать все негативные факторы, связанные с патологическим процессом. Врач назначает мазок из уретры:
- с профилактической целью;
- при инфекционных недугах;
- при наличии сильного зуда;
- чтобы выяснить причины дискомфорта в мочеиспускательном канале;
- при наличии воспаления в мочеполовой системе мужчины;
- чтобы проверить выделения, имеющие неприятный запах.
Следовательно, мазок из уретры — уникальная возможность определить, какие лучше всего подобрать медикаменты, чтобы устранить конкретный тип инфекционного недуга. Такие анализы позволят выявить негативные микроорганизмы в мужском мочеиспускательном канале. В итоге специалисты смогут предотвратить их последующее распространение и устранить различные осложнения, которые могли проявиться.
Даже скрытые инфекции при мазке из уретры поддаются обследованию. Такой материал тщательно проверяют микроскопом. Затем специалист составляет общую характеристику микрофлоры в мочеиспускательном канале.
Анализ даст возможность выявить количество и тип болезнетворных бактерий, содержание лейкоцитов и эритроцитов, характеристику и состав микрофлоры, провести анализ вредоносных бактерий и различных грибков.
Взятие мазка дает возможность выявить целый перечень заболеваний, очаг которых локализуется непосредственно в уретре. Но бывают случаи, когда специалисту не удается полностью исследовать мазок через микроскоп. Это актуально при наличии скрытых инфекции.
Тогда рекомендуется помимо мазка из уретры сдать культуральный анализ, представляющий собой количественное определение микроорганизмов, обитающих в мужском мочеиспускательном канале. Кроме того, применяется методика полимеразной цепной реакции. Она позволяет определить различные заболевания, передающиеся в процессе интимной близости.
Анализ мазка из мочеиспускательного канала актуален при подозрении на простатит, уретрит, хламидиоз, гонорею, трихомониаз, уреаплазмоз.
Нельзя недооценивать такую процедуру. Ведь нередко именно она позволяет своевременно выявить патогенный процесс и определить наиболее эффективный терапевтический подход, который поможет избежать множества неприятных осложнений, а также последствий. При наличии подозрений на заболевания мочеполовой системы и даже при незначительном дискомфорте в зоне уретры целесообразно обратиться к врачу.
Источник:
Причины назначения мазка из уретры у мужчин
Мазок из уретры у мужчин — это важная урологическая манипуляция. При обнаружении тех или иных симптомов, появление которых не является нормой, чаще всего именно мазок на флору поможет прояснить картину патологии.
Мазок у мужчин определяет:
- компоненты микрофлоры;
- наличие патогенных микроорганизмов, виновных в гнойных процессах;
- факт развития воспаления;
- наличие возбудителя венерических заболеваний;
- любую патогенную микрофлору: от вируса, до грибка.
Что показывает анализ
Этот анализ позволяет определить наличие и численность бактерий в мочеполовой системе, а в частности в мочевом канале.
Кроме того, только мазок позволяет определить, какие виды микроорганизмов стали причиной воспаления в организме.
Мазок у мужчин может быть взят в момент приема у врача — уролога или с целью определения причин появления выделений, высыпаний или болезненных ощущений во время мочеиспускания или секса.
С помощью данного исследования удается оценить общую работу и состояние выделительной и половой систем мужчины, а также исключить или констатировать факт воспаления.
Что касаемо метода обследования, то берется анализ на бактериологический посев из уретры мужчины.
Болевые ощущения при процедуре
Для получения материала в достаточном количестве в канал уретры пациента вводят зонд. Глубина равна 3 см. Естественно, что используемый инструмент полностью стерильный и одноразовый. Итак, зонд после ввода прокручивают, собирая выделения, после этого извлекают и кладут в лабораторную пробирку. Она должна быть стерильной на 100%.
Чаще всего эта манипуляция доставляет явный дискомфорт, но некоторые мужчины могут испытывать боль в исследуемой области продолжительностью до нескольких часов.
Сама процедура занимает около четверти часа, а результат готов, как правило, в течение 7 дней.
То есть, в большинстве случаев, проведение анализа неприятно для мужчины, но боль несильная. Врачи могут советовать провести накануне исследования массаж простаты или самого канала, чтобы снизить возможные болезненные ощущения.
Диагностика заболеваний
Многие представители сильного пола интересуются, какие заболевания можно диагностировать с помощью анализа отделяемого из мочеиспускательного канала. Обычно врач не может назвать причины появления признаков патологии или воспаления на глаз, а ставит диагноз только после получения точного лабораторного анализа.
Анализ на флору дает возможность урологу определить, какое именно заболевание имеет место быть в организме у мужчины.
Виды заболеваний мужской мочеполовой сферы:
- Простатит.
- Уретрит и уреаплазмоз.
- Хламидиоз и гонорея.
В случае необходимости врач может назначить ПЦР для определения численности патогенных микроорганизмов и их типа.
Показания для проведения бактериологического исследования
Зачастую мазок из уретры имеет показание в профилактических целях. Эта манипуляция помогает определить причину имеющихся симптомов или общее состояние мочеполовой системы мужчины. Этот анализ важен при планировании беременности у женщин, когда врач проводит обследование пары.
Признаки, как сигнал к проведению анализа флоры, то есть наличие:
- жжения и сильного зуда в области мочеиспускательного канала;
- боли и дискомфорта при мочеиспускании или половом акте;
- нехарактерных выделений из исследуемой области;
- аллергии под видом сыпи и покраснений на органах половой сферы;
- любого вида боли на половых органах: от ноющей и тянущей, до острой и тупой.
Подготовка к забору и расшифровка результатов
Как правило, взятие любого мазка предполагает соблюдение рекомендаций. Это позволит получить наиболее точный результат исследования.
Рекомендации перед взятием мазка на флору:
- воздержание от половой жизни за 2 суток для исследования;
- проведение гигиенических процедур перед сном, но не перед визитом на анализ;
- за 2 часа до сдачи анализа не мочиться, дабы не «смазать» картину результатов;
- за 7-10 дней до того, как берется соскоб из уретры, стоит отменить прием всех препаратов, не предписанных лечащим врачом.
Расшифровка результата мазка осуществляется только врачом, однако описание неких терминов поможет понять, что происходит в организме.
- Присутствие лейкоцитов. Когда микрофлора в норме, содержание малого количества лейкоцитов допустимо. Эти клетки выполняют защитную функцию. То есть, если их численность увеличивается, то речь идет о наличии в организме воспалительного процесса. Допустимое количество лейкоцитов 0-5. Когда показатель лейкоцитов сильно выше нормы, то чаще всего причина в развитии простатита или уретрита у мужчины.
- Эпителий в мазке из мочеиспускательного канала. Эпителиальной тканью выстлана внутренняя поверхность мочеиспускательного отверстия . Норма количества эпителия в мазке от 5 до 10. В случае отхождения от нормы диагностируется воспалительный процесс.
- Слизь в мазке: что означает? В норме слизи должно быть умеренное количество, в противном случае, показатель говорит об инфекции.
- В мазке стрептококки, стафилококки или энтерококки: что означает? Эти микроорганизмы способны к размножению только при благоприятных для них условиях. В случае, когда их количество умеренное, то страшного ничего нет. Если кокки обнаружены в большой концентрации, то можно полагать, что есть уретрит.
- В мазке гонококки: что означает? Для здорового мужчины присутствие гонококков в мазке на флору недопустимо. Если они обнаружены, то можно диагностировать гонорею.
- В мазке трихомонады: что означает? Ситуация та же: наличие трихомонад в здоровом организме недопустимо. Их выявление является подтверждением трихомониаза.
Читайте также: Радикальная простатэктомия в лечении рака простаты
Для организма мужчины допустимо присутствие некоторых микроорганизмов в умеренном количестве.
Нормальные показатели флоры:
- Эпителия от 5 до 10.
- Лейкоцитов от 0 до 5.
- Кокков — единичное количество.
- Слизи — умеренное количество.
- Гонококков — не должно быть.
- Трихомонад — не должно быть.
Полезные рекомендации
Мужчины, как правило, не спрашивают у врача, что следует делать после анализа из уретры и есть ли какие-либо предписания. На самом деле, правил, кроме как наблюдение за своим организмом, нет. Нужно быть готовым к тому, что могут появляться продолжительные ощущения боли или дискомфорта в области забора материала на анализ.
Однако боли могут усиливаться, что не стоит оставлять без внимания. Боли продолжительностью в несколько дней и появление выделений, похожих на гнойные, являются поводом срочного похода на прием к урологу.
Действия при патологии
Не все мужчины осведомлены о том, как себя вести и что предпринимать в случае плохого мазка. Стоит отбросить в сторону панику, когда результат неутешительный. Любое заболевание мочеполовой сферы, определяемое мазком на флору, вполне можно вылечить.
Действия при плохом анализе:
- Обратиться к врачу и получить направление за дополнительными анализами, по результатам которых специалист назначит необходимое лечение.
- В случае серьезных отклонений от нормы и выявления конкретной инфекции врач — уролог назначает должную схему лечения.
- Самолечение полностью исключается, только врач может назначить его, сопоставив результаты анализа на флору.
В некоторых случаях наличие патологии микрофлоры мочеиспускательного канала может служить причиной бесплодия в будущем. Запущенные случаи могут отрицательно влиять на качество спермы. То есть семенная жидкость будет содержать неподвижные сперматозоиды.
Игнорирование плохих результатов мазка на флору из уретры недопустимо. В противном случае последствия будут плачевными.
Инфекция может способствовать быстрому развитию заболевания, а потому бездействие приведет к его переходу в хроническую форму. Тогда болезнь может обостриться и вылечить ее до конца станет невозможным.
Инфекция без лечения — это путь к импотенции и даже бесплодию.
Очень часто недуг протекает в скрытой форме или с исчезающими время от времени симптомами. Даже если есть малейшее подозрение на проникновение инфекции или развитие заболевания мочеполовой сферы, немедленно стоит идти к врачу. Думать, что признаки и болезнь пройдут сами по себе, ошибочно.
Можно подвести итог, что мазок у мужчин на флору из уретры является одним из самых информативных, доступных и быстрых исследований для выявлений проблем с мужским здоровьем.
Если анализ был сдан на первых порах обнаружения симптомов, то вероятность эффективного лечения и минимума последствий очень высока. Не стоит затягивать с походом к врачу, особенно если мужчина ведет половую жизнь.
Партнерше тоже стоит сдать анализы, если у мужчины результат оказался положительным.
Лечение назначается комплексное, согласно типу выявленного возбудителя. Это могут быть противовирусные препараты, антибиотики, местная терапия и препараты для повышения защитных сил организма. Своевременное обращение к врачу, подготовка к проведению анализа и должная схема лечения — это залог быстрого и эффективного выздоровления для мужчины.
Как берут мазок у мужчин на инфекции?
Как берут мазок у мужчин, интересуются, если в скором времени предстоит проходить данную процедуру.
Поскольку манипуляция производится в достаточно деликатной области, неудивительно, что многие мужчины ее опасаются. В некоторых случаях они даже склонны отказываться от обследования, чего ни в коем случае не надо делать.
Процедура по взятию мазка представляет собой соскоб небольшого количества ткани для дальнейшего изучения в условиях лаборатории. Эта форма исследования отличается простотой и скоростью осуществления. С ее помощью можно определить наличие болезней, имеющих разный характер.
Мазок в урологии назначается к выполнению с целью определения состава и качества микрофлоры канала мочеиспускания. Чтобы поставить диагноз, необходимы не только рассказы пациента о беспокоящих его симптомах, но и лабораторные исследования, которые в большинстве случаев могут быть ограничены одним мазком.
Длина уретры у мужчин составляет примерно 20 см, диаметр — 8 мм. Через нее выводится наружу моча или семенная жидкость. У мочевыводящего канала имеется особая микрофлора, которая характеризуется наличием стафилококков.
Но микроорганизмы располагаются в самом начале уретры — примерно на протяжении 5 см от ее края, а дальше канал полностью стерилен. Поэтому, для того чтобы взять мазок из уретры, понадобится вводить ватный тампон внутрь примерно на 4 см.
Показания к исследованию
Мужчины чересчур редко обращаются за медицинской помощью к урологам — намного реже, чем это необходимо. Обычно врачу наносят визит в случаях, когда организм одолели какие-либо инфекции, симптомы болезни усиливаются и дискомфортные ощущения становятся нестерпимыми. Общеизвестные средства в таких ситуациях не помогают.
В такой ситуации последствия могут быть крайне неблагоприятными, поэтому требуется как можно быстрее пройти необходимые исследования, на основании которых доктор может делать выводы и составлять план лечения.
Брать мазок из уретры могут назначить в следующих случаях:
- если отмечены дурнопахнущие выделения из канала;
- если есть вероятность инфекции в организме;
- для профилактической цели;
- при выявлении воспалительного процесса, который протекает непосредственно в мочевыделительной системе;
- при ощущении дискомфорта в районе уретры.
Мазок нередко выступает в качестве сопутствующего анализа. Часто его назначают, если предположительно имеются инфекции в результате воздействия бактерий.
По результатам полученных анализов можно будет рассуждать о том, каков состав микрофлоры, соответствует ли норме ее качество, а также судить о прочих, не менее важных характеристиках. Все это помогает сделать выводы, на основе которых будет назначаться лечение. Но прежде необходимо изучить под микроскопом собранный материал.
При совершении исследования можно прояснить:
- состав флоры;
- наличие грибков;
- содержание лейкоцитов;
- нет ли вредоносных бактерий и микроорганизмов;
- наличие бактерий, которые способны развить образование и скапливание гноя;
- наличие эритроцитов.
Как проходит процедура?
Несмотря на то что уролога рекомендовано посещать для профилактики болезней хотя бы раз в год, мужчины делают это крайне редко и с большой неохотой. Часто причиной становится боязнь процедур. Поэтому мужской пол всегда интересует, как берут мазок, насколько это болезненно и нельзя ли избежать процедуры.
Материал для проведения исследований сначала берут из уретры, затем направляют его в лабораторию для выполнения всех необходимых процедур. Манипуляцию осуществляет уролог. Нельзя подтвердить, что она полностью безболезненна и любые ощущения дискомфорта отсутствуют, но особенных болевых проявлений испытывать не придется.
Если же при взятии мазка отмечена сильная боль, это в большинстве случаев свидетельствует о повреждении мочеиспускательного канала, воспалительном процессе внутри него или инфекционной болезни.
При повреждении ткани уретры во время взятия материала болезненные ощущения нередко усиливаются. Но если человек здоров, максимум, что может доставить процедура, — легкий психологический дискомфорт.
Для процедуры чаще используют стерильный ватный тампон с узким аппликатором. Его вводят в уретру на длину, не превышающую 4 см. Затем, аккуратно вращая, извлекают. Вместо него могут использоваться ложка Фолькмана или бактериологическая петля.
В лабораторных исследованиях возможно изучение клеток эпителия, которые остались на конце тампона либо аппликаторе.
Вся процедура занимает не больше 2 минут. Что касается неприятных ощущений, не стоит отказываться от исследования только по этим соображениям. При отсутствии результатов анализа лечение отодвинется на неопределенный срок. Здоровью при этом может быть нанесен непоправимый ущерб.
Для получения максимально информативного результата необходимо перед сдачей анализа соблюдать такие правила:
- за 6-7 дней до проведения анализа окажитесь от приема антибиотических средств и сильнодействующих препаратов;
- за пару дней исключите алкоголь;
- половые контакты не должны быть позже чем за 12 часов до процедуры;
- посетите туалет за 2 часа до мазка и больше не ходите туда, пока анализ не будет сдан.
Информативность исследования
Если результаты анализа не особенно утешительны, пациенту назначается лечение. Но и при хороших показателях не гарантировано полное отсутствие болезнетворных микроорганизмов. Это объясняется тем, что далеко не все виды микроорганизмов можно определить при помощи мазка. Последний позволяет обнаружить кандид, гарденерелл, могут быть отмечены трихомонады, гонококки, порой хламидии.
Исследования биоматериала осуществляются при помощи микроскопа. Остается вероятность, что некоторые микроорганизмы могут оказаться незамеченными.
Можно заключить, что мазок относится к малоинформативным, но и самым простым исследованиям уретры, которое поможет определить наличие и количество некоторых болезнетворных организмов. Оно не потребует много временных или финансовых затрат, зато послужит хорошим подспорьем урологу при назначении лечения.
Как берут мазок у мужчин
- Особенность процедуры и ее необходимость
- Выявление болезней при взятии мазка
- Процесс взятия мазка у мужчины
- Подготовка к процедуре
- Результаты анализов
- Некоторые важные моменты
Одной из недорогих и легкодоступных форм анализа в урологии является взятие мазка у мужчин. Суть данной процедуры заключается в лабораторном изучении тканей, которые с помощью специальной методики изымаются из уретры. Мазок является ценным средством, позволяющим оперативно выявить и проанализировать множество видов заболеваний. Также с помощью этого материала, который выбирается из мужской уретры, специалисты могут проверить состав и качество микрофлоры в мочевыводящем канале. На практике бывают случаи, когда для диагностирования определенных заболеваний требуется только лабораторный анализ мазка.
Читайте также: Опасность и вред ночного храпа для здоровья
Для проведения этой процедуры исследования применяется специальный тампон ватного типа. Для успешного взятия мазка из мочеиспускательного канала его достаточно ввести в уретру на 4-5 см. Это связано с тем, что практически все микроорганизмы находятся именно на этом небольшом участке мужского полового органа.
Поэтому врач-уролог всегда берет мазок для дальнейшего исследования с этой части уретры, невзирая на ее длину в 20-22 см.
Особенность процедуры и ее необходимость
В очень многих ситуациях мужчины обязаны обращаться за помощью к специалисту по урологии. Для полноценного и качественного исследования им необходимо сдать мазок из уретры. Такой специальный анализ дает возможность врачу определить, какие типы микроорганизмов и в каких количествах находятся в мочеиспускательной системе мужчины.
Посредством взятия мазка специалист в очень короткое время сможет выяснить наличие инфекционного очага в этой области мужского полового органа и, соответственно, назначить определенный курс лечения.
Практически все врачи перед тем, как берут материал для анализа, всегда консультируют пациента и выясняют основные симптомы возникшей проблемы.
Часто в мужском организме находится скрытая инфекция, которую очень трудно определить обычными методами исследования, например, с помощью анализа крови. Человек может и не догадываться, какие именно симптомы могут быть при таких заболеваниях, и обращается к врачу только в случае сильного обострения проблемы.
Поэтому урологи часто берут и проверяют мазок у мужчин на скрытые инфекции. Своевременное выявление вредных микроорганизмов всегда способствует предотвращению их дальнейшего развития и нейтрализует все негативные факторы, которые связаны с этим процессом.
Врач может назначить взятие мазка из уретры в таких случаях:
- анализ с целью профилактики;
- в случае инфекционных заболеваний;
- при наличии воспалительных процессов в системе мужских половых органов;
- для проверки выделения, которое характеризуется неприятным запахом;
- при сильном зуде;
- с целью выяснения причины дискомфорта в уретре.
Больно ли брать мазок у мужчин: особенность и необходимость процедуры
Мазок мужчине назначается при подозрении на какие-либо заболевания или же в качестве профилактической меры, например, при планировании зачатия ребенка. Сдача мазка обязательна при наличии следующих жалоб:
- болевые ощущения при сексе или при попытке опорожнить мочевой пузырь;
- выделения из головки полового члена неясной этиологии;
- раздражение или высыпание на поверхности интимного органа, провоцирующее жжение и зуд;
- затруднение выхода мочи при мочеиспускании;
- подозрение на наличие заболеваний, передающихся половым путем;
- постоянные гинекологические или урологические проблемы у партнерши, связанные с ПА;
- многочисленные неудачные попытки зачатия.
Плюсы и минусы исследования
Взятие мазков из уретры у мужчин имеет несколько недостатков. К их списку относят исключительно наличие противопоказаний к проведению процедуры. Брать материал на анализ нельзя при повышенной температуре тела, сопутствующих воспалительных процессах в организме, при выделении крови из головки члена, при алкогольном опьянении. Факторы могут отразиться на достоверности результата анализа.
Из преимуществ обследования отмечаются оперативность и малоинвазивность. Забор материала для исследования занимает короткий промежуток времени и абсолютно безболезнен. Результаты довольно информативны и сообщают о патологиях, находящихся на стадии развития.
Какие патологии можно обнаружить
Данная урологическая манипуляция является информативной и способна сообщить не только об имеющихся инфекционных процессах, но и о состоянии микрофлоры, присутствии возбудителей недугов, патогенных микроорганизмов. Мазок из уретры показывает следующие заболевания:
- воспаление мочевого пузыря;
- простатит;
- воспаление уретры.
Процедура выявляет такие патогенные микроорганизмы и инфекции:
- грибы Candida;
- хламидиоз;
- трихомониаз;
- микоплазмоз;
- золотистый стафилококк;
- синегнойная палочка;
- кишечная палочка и др.
Также с помощью взятия мазка у мужчин выясняется, где именно локализован патологический процесс — в мочевом пузыре или мочеиспускательном канале.
ПЦР для выявления ИПП
Кроме взятия мазка на флору, биоматериал еще используют для получения информации о скрытых половых инфекциях. Процедура проходит стандартно. Далее мазок в стерильной емкости отправляют на изучение.
С помощью метода ПЦР у мужчины можно обнаружить следующие инфекции:
- уреаплазма;
- микоплазма;
- трихомонада;
- гонококк;
- цитомегаловирус;
- вирус простого герпеса.
После дополнительных обследований перечень может расширяться или сужаться.
Именно этот анализ считается самым эффективным, так как позволяет найти инфекции, развивающиеся скрытно, без симптомов.
Как подготовиться ко взятию мазка
Чтобы добиться максимальной достоверности, к предстоящей процедуре нужно тщательным образом подготовиться. Обычно перед назначением анализа доктор объясняет подобные нюансы. Рассмотрим, как проводится подготовка к мазку из уретры:
- За неделю до предстоящего исследования мужчине нужно отказаться от приема медикаментозных средств, которые не являются жизненно необходимыми. В особенности это касается гормональных, антибактериальных и противовоспалительных средств.
- За трое суток до забора мазка стоит ограничить половую жизнь. Это касается не только секса, но и мастурбации.
- Вечером, перед утренней манипуляцией, мужчине необходимо произвести гигиенические процедуры, касаемо полового члена. Следует отметить, что утром мыть или чем-либо обрабатывать орган строго запрещено.
- Осуществить акт мочеиспускания разрешено не менее чем за 3 часа до взятия мазка на исследование.
При проведении гигиенических процедур накануне откажитесь от ароматизированных косметических средств. Делать подмывания можно с помощью обычного детского мыла.
Как производится забор материала для исследования
В первую очередь стоит отметить, что берут мазок у мужчины из уретры исключительно врачи-урологи, ни в коем случае не медицинские сестры. Это обусловлено тем, что манипуляция требует правильного выполнения — малейшее излишнее движение повредит слизистые оболочки, что приведет к болевым ощущениям и другим неприятным симптомам.
Доктор берет мазок на флору из уретры у мужчины с помощью небольшого зонда, который вводят в мочеиспускательный канал примерно на 3-4 сантиметра. Далее лаборант наносит биологический материал мужчины на специальное стекло. Спустя некоторое время предметное стекло с мазком из уретры изучают под микроскопическим прибором.
Болезненность процедуры
Многие мужчины отказываются сдать анализ из уретры по причине страха боли. Большинство согласны болеть дальше, но к данному мероприятию не готовы. На основе многочисленных отзывов можно сделать вывод, что процедура безболезненна, но все-таки неприятна. Боль иногда возникает из-за неправильной техники выполнения.
При наличии острой инфекции в мочеиспускательном канале, процедура может быть несколько болезненной. Мочеиспускание после нее может быть затруднено. Могут даже появиться небольшие кровянистые выделения в моче.
Некоторые пациенты жалуются, что после забора мазка для ПЦР возникают неприятные жгучие ощущения в половом члене, которые значительно усиливаются при мочеиспускании. На самом деле такая реакция является естественной и не требует лечения. Спустя сутки неприятные признаки проходят самостоятельно.
Также существует мнение, что сильную боль при введении зонда испытывают мужчины, у которых возникло воспаление и припухлость уретры. В таком случае процедура заменяется альтернативной — бак посев мочи.
Эффективность данной манипуляции высока только в том случае, если у мужчины наблюдаются патологические процессы в мочеиспускательном канале или в мочевом пузыре.
Никаких инфекций, передающихся половым путем, общая диагностика не выявит.
При отсутствии острых воспалений и профессионализме врача, проводящего процедуру, манипуляция не является болезненной, побочные эффекты после нее отсутствуют либо являются минимальными. В случае сохранения неприятных ощущений или их нарастании через сутки после взятия мазка, следует обратиться к лечащему врачу.
Возможные последствия
В том случае, если боль после мазка из уретры у мужчины появилась и сохраняется дольше 3 дней, пациенту нужно срочно обратиться в больницу. Также может наблюдаться длительное кровотечение при мочеиспускании, что не является нормой.
Нередко болевые ощущения и жжение сопровождаются гнойными выделениями с неприятным запахом. В таком случае речь идет о заражении во время проведения манипуляции.
При своевременном обращении к доктору прогнозы весьма благоприятные.
Стоимость процедуры
В зависимости от региона цены варьируются. К тому же, пациент может сдавать анализ в различных местах, от чего стоимость тоже меняется. К примеру, в обычной поликлинике платная услуга стоит дешевле, нежели в медицинской клинике высшего класса.
Средняя цена забора и исследования мазка из уретры составляет 350-500 рублей.
Расшифровка: какие показатели считают нормой
В ходе изучения анализа лаборанты основываются на следующих показателях:
- Трихомонады. При отсутствии заболевания плоские микроорганизмы, передающиеся половым путем, в мазке отсутствуют.
- Эпителий. Должны присутствовать в пределах от 5 до 10. Если показатель превышает норму — у мужчины имеется воспалительный процесс мочеиспускательного канала.
- Слизь при отсутствии патологии в мазке наблюдается в минимальном количестве.
- Лейкоциты. Данные иммунные клетки в обязательном порядке содержатся в мазке из уретры. Показатель нормы варьируется от 0 до 5. Если цифра увеличена хотя бы на одно деление, речь идет об инфекции, которую нужно лечить медикаментозными средствами — цистит или простатит.
- Грибки кандида. Отсутствуют при норме.
- Гонококки. Наличие данных микроорганизмов свидетельствует о гонорее у мужчины. У здорового человека они отсутствуют.
Если результат плохой
Не стоит отчаиваться и опускать руки при обнаружении ИППП или же при диагностировании заболевания уретры. Для начала следует повторно пересдать мазок, желательно в другом месте, чтобы исключить ошибку.
Если результат снова подтвердился, следует внимательно выслушать доктора и в ближайшее время приступить к лечению патологии.
Ни в коем случае нельзя заниматься самолечением, так как каждая инфекция в мазке лечится по-разному.
Терапевтические меры
Лечение после получения результатов сугубо индивидуально. Как было сказано, для каждого вида инфекции или заболевания требуются различные методы терапии. Рассмотрим основную тактику лечения:
- Нормализация питания. Исключается вся вредная пища, рацион обогащается диетическим мясом, крупами, фруктами и овощами. В дополнении могут быть назначены витаминизированные курсы.
- При выявлении бактерий назначают препараты антибиотической группы. Прежде, чем конкретный медикаментозный препарат будет выбран, необходимо провести чувствительность возбудителей к антибиотику.
- Если патологический процесс вызван грибками, доктор выписывает антимикотические препараты.
- При наличии воспаления могут потребоваться противовоспалительные и противомикробные средства.
- При проблемах с предстательной железой назначают препараты на растительной основе совместно с антибиотиками в виде инъекций.
Курс лечения и необходимые медикаменты выписывает исключительно врач-уролог.
Показания к исследованию
Как известно, представители мужского пола крайне редко посещают уролога — когда симптомы невозможно терпеть. А это неправильно, так как заболевание может оказаться очень серьезным, а последствия — непредсказуемые. Соскоб из уретры назначают в следующих случаях:
- для профилактики недуга;
- при инфекционных болезнях;
- при воспалении в мочевыделительной системе;
- при наличии выделений, неприятного запаха, раздражения;
- при болевых ощущениях во время полового акта или мочеиспускания.
Результаты взятия мазка из уретры на микрофлору показывают:
- присутствие бактерий и микроорганизмов;
- состав флоры;
- наличие лейкоцитов и эпителия;
- наличие грибков и паразитов.
Подготовка мазку из уретры у мужчины
Подготовка к процедуре необходима. До взятия мазка из уретры нужно воздержаться от мочеиспускания на целых 2 часа. Мужчина должен вымыть область анального отверстия, промежность и мужской орган, желательно перед самым приемом.
Мыться в теплой воде с мылом, после чего ополоснутся и вытереться салфетками. Обязательно воздержаться от интимных связей за 2 дня до того, как сдавать мазок из уретры.
Читайте также: Отчего появляются мешки под глазами у мужчин?
Отказаться от приема медикаментов за 7 дней, если лечение нельзя прекращать, то бак посев из уретры у мужчин будет перенесен на позже.
Как сдают забор материала?
Забор мазка в уретре — очень быстрая и простая техника. Только после тщательной подготовки пациента доктор проводит общий осмотр. Мазок из уретры берется новым и стерильным инструментом. С его помощью врач делает несколько поворотов и вынимает. Посев на флору помещают в пробирку. Взятие мазка из уретры занимает не больше 2-х минут.
Иногда, чтобы получить достоверный результат по скрытым инфекциям, делается массаж мочеполовых органов, чтобы увеличить чувствительность к проводимому анализу. Также проводится ПЦР-диагностика. Она показывает наличие и количественный состав вредных бактерий. Посев из уретры наносят на специальные стекла, высушивают на открытом воздухе и красят.
Дальше микроскопия подскажет реакцию частиц.
Больно ли пациенту после процедуры?
Забор мазка на инфекции иногда вызывает болевые симптомы, а также дискомфорт после процедуры, а при мочеиспускании зуд и жжение. В итоге, боль после мазка из уретры у мужчин — нормальное явление. Но нужно прислушиваться к своему организму.
Ведь болевые ощущения могут усиливаться, а это уже повод для беспокойства. Если пациент наблюдает, помимо болевого синдрома, еще и выделения, то визит к врачу-урологу откладывать никак нельзя.
Возможно, в организме уже имеются воспалительные процессы, которые после процедуры только усугубились.
Расшифровка показателей
Расшифровать анализ мазка может только уролог. Доктор обращает свое внимание на количественный состав определенных клеток, что имеет мазок на флору, и наличие вредных микроорганизмов. После чего больной получит результаты и от этих сведений зависит дальнейшее лечение. Ошибка в показаниях анализа покажет в дальнейшем серьезные последствия.
Когда считается норма?
Наличие в организме некоторых бактерий у мужчин считается нормой. Показать хорошие анализы могут такие данные:
- эпителий — норма от 5 до 10;
- лейкоциты — не больше 5;
- кокки — единичное количество;
- слизи — умеренное количество;
- гонококки и трихомонады — отсутствуют.
Наличие лейкоцитов
Первое, что интересует нас в анализе — это число лейкоцитов. Их количество не должно превышать диапазон от 0 до 5. Если количественный состав намного больше, то это свидетельствует о воспалительных процессах. Когда повышение вызвано нейтрофилами или лимфоцитами, то в организме развивается острая форма уретрита. А когда эозинофилы влияют, то пациент подвержен аллергическому проявлению.
Эпителий в анализе
Эпителий — это отслоившиеся клетки от слизистой. Если при исследовании обнаружено больше, чем 10 клеток эпителиальной ткани, то это значит, что пациент болен хроническим уретритом.
Наличие крови может указывать на травмы уретры, опухоль или язвенные процессы в уретре. Воспалительный процесс в острой форме характеризует высокий состав как лейкоцитов, так и эпителиальной ткани.
Если же количественный состав эпителия намного выше лейкоцитов, то в организме протекают хронические болезни.
Выявление слизи
Слизь в мазке указывает на уретрит, а также травмирования и новообразования в уретре.
Слизь может наблюдаться в совсем небольшом количестве, а большой количественный состав указывает на присутствие в организме трихомонад, хламидий, кандиды и разнообразных кокков.
О наличие инфекции в острой форме подскажет повышенный состав слизи совместно с эпителиальной тканью и лейкоцитами. Если в организме хроническая форма заболевания, то эпителиальной ткани и слизи окажется намного больше, чем лейкоцитов.
Нормальная микрофлора
Вследствие исследования нормальное явление — кокки в единичных числах, но их изобилие указывает на неспецифический уретрит.
Мазок здорового мужчины не должен содержать гонококки, также трихомонады и грибки, если они наблюдаются, соответственно, произошло инфицирование.
Чтоб определить заболевания, как микоплазмоз, хламидиоз и генитальный герпес, нужен только ПЦР-анализ. Если жалоб нет, все равно рекомендуется проходить раз в год осмотр в качестве профилактики.
Мазок у мужчин на флору: как его берут и какие болезни выявляют
Мазок из уретры у мужчин ‒ это один из обязательных видов исследований у уролога. Нет ни одного мужчины на свете, который ни разу в жизни не проходил осмотр у врача-уролога. Даже на профилактическом осмотре доктор в обязательном порядке берет соскоб из мочеиспускательного канала для поиска различной инфекции.
Особо пристальное внимание результатам исследования уролог уделит при наличии симптомов заболеваний. С помощью результатов обследования выясняют состояние мочеполовой системы, наличие патогенных микроорганизмов (кокки, трихомонады и другие) и признаков воспаления.
Как берут мазок у мужчин и как проходит расшифровка результата, больно ли сдать анализ на флору, как зависит лечение от результатов, рассмотрим подробнее.
Анализ поможет выявить наличие различных заболеваний моче-половой системы.
Как проходит забор материала
Прежде чем сдать на анализ материал из уретры мужчине следует подготовиться: провести тщательный туалет половых органов (эту процедуру лучше всего выполнить перед сном, а не с утра), воздержаться от сексуальных отношений как минимум за 2 суток до планируемого посещения уролога. Если перед приемом у специалиста мужчина принимал антибиотики, которыми он лечил другие инфекции, то следует предупредить об этом врача.
Уролог перенесет дату сбора материала на более поздний срок, как минимум на 2 недели, после приема последней дозы антибактериального препарата. Анализ на флору берется не раньше чем спустя 2-3 часа после опорожнения мочевого пузыря.
Если пренебречь приведенными правилами, то показатели будут искажены и назначено неверное лечение. Особенно это важно, если присутствует патогенная флора в организме, такая как различные кокки, диплококки (гонорея), трихомонады и другое.
Мазок берут из уретры и наносят на предметное стекло. Его, в свою очередь, оставляют для изучения в лаборатории с целью поиска патогенной флоры. Часть материала направляют на ПЦР-анализ.
В некоторых случаях врач берет соскоб только для изучения на определенную флору.
Либо соскоб берется только на определение скрытых патологий, который могли вызвать кокки либо другие бактерии, либо таким образом начинают мониторить лечение текущего заболевания.
После процедуры в течение некоторого времени мужчина испытывает дискомфорт. Вероятны зуд и жжение, а также может быть больно во время мочеиспускания.
Как оценивают результат?
Расшифровка ответа лаборатории проводится только специалистом. От достоверности чтения исследования на флору зависит постановка диагноза и лечение обнаруженных заболеваний или скрытых патологий. Что ищет лаборатория в мазке?
Лейкоциты
Повышенное содержание лейкоцитов в исследуемом материале не обязательно может означать наличие инфекции.
Анализ на флору допускает присутствие лейкоцитов в малых количествах ‒ до 5 штук.
Если расшифровка результатов мазка показала, что в материале больше 5 штук, то это означает, что в органах мочеполовой системы мужчины происходит патологический процесс, который могли вызвать различные кокки или другие виды патогенной микрофлоры. Причиной их появления способны быть как инфекции, так и новообразования в уретре или простате.
Об этом более подробно расскажет расположение таких клеток на предметном стекле. Если же лейкоцитов в поле зрения больше 100 штук, то врач вправе заподозрить гонорею или трихомониаз. Возбудителя или вид новообразования определяет только доктор, назначив дополнительное обследование. От его достоверности будет зависеть лечение патологии.
Эпителий
Эпителий ‒ это слущенные с поверхности слизистой оболочки клетки. В норме они могут содержаться в материале, но не более 10 штук в поле зрения. Если численность эпителиальных клеток в мазке на флору превышает 10 штук, то это означает, что в уретре идет патологический процесс и там могут присутствовать различные кокки, трихомонады и другие бактерии.
Особо важен такой показатель в совокупности с лейкоцитами. Острый воспалительный процесс проявит себя одинаковым количеством лейкоцитов и эпителиальных клеток.
При хроническом течении заболевания эпителий будет доминировать над лейкоцитами. Также эпителий в мазке указывает на возможные воспалительные процессы после травмы, опухоли, язвенное поражение и присутствие инфекции.
Лечение заболеваний зависит от ответа лаборатории.
Слизь
Слизь в мазке содержится в небольшом количестве. Если же в мазке замечено большое содержание слизи, то такое означает, что в мочевыводящих путях мужчины при более тщательном обследовании реально обнаружить патогенную флору. Это могут быть:
- Диплококки.
- Трихомонады.
- Кандиды.
- Разнообразные кокки.
- Хламидии и другие патологические микроорганизмы.
Наличие небольшого количества слизи считается допустимой нормой.
Сочетание повышенного содержания слизи, лейкоцитов и эпителия в мазке обозначает проявление инфекции в остром процессе. Если же в мочевыводящих путях присутствует хроническая патология, то слизь и эпителий будут превышать численность защитных клеток крови. Эта комбинация также указывает на скрытое воспаление.
Микрофлора
В норме в мазках могут содержаться единичные кокки. Если же расшифровка исследования на флору показала присутствие в мазке более 5 микроорганизмов в поле зрения, то такое указывает на дисбактериоз мочеполовой системы.
Это и явилось причиной того, что в мочевыводящих путях размножились кокки (диплококки, стафилококки) и другие виды инфекции, которые вызывают воспаление.
Лечение будет назначено после того, как проведут анализ на чувствительность таких возбудителей к антибиотикам.
Диплококки, трихомонады и грибы в мазке в норме должны отсутствовать. Если лабораторный анализ выявил диплококки (гонококки), то это значит, что произошло заражение гонореей. Присутствие трихомонад указывает на трихомониаз, а наличие грибков в мазке расскажет о грибковом поражении, самым распространенным из которых является поражение грибками рода Кандида.
Мазок на флору из уретры, который берут у мужчин, имеет важное значение в урологии и венерологии.
С его помощью врач не только определяет наличие воспалительных процессов в мочеполовых органах мужчины, но и фиксирует тип инфекции.
Такие показатели определяют правильное лечение и помогают избежать ошибок в диагностике. Потому анализ мазка на инфекции, если он назначен урологом, сдать нужно, даже если это и больно.
Больно ли брать мазок у мужчин: особенность и необходимость процедуры
Дождитесь окончания поиска во всех базах.По завершению появится ссылка для доступа к найденным материалам.
Особенность процедуры и ее необходимость
В очень многих ситуациях мужчины обязаны обращаться за помощью к специалисту по урологии. Для полноценного и качественного исследования им необходимо сдать мазок из уретры. Такой специальный анализ дает возможность врачу определить, какие типы микроорганизмов и в каких количествах находятся в мочеиспускательной системе мужчины. Посредством взятия мазка специалист в очень короткое время сможет выяснить наличие инфекционного очага в этой области мужского полового органа и, соответственно, назначить определенный курс лечения. Практически все врачи перед тем, как берут материал для анализа, всегда консультируют пациента и выясняют основные симптомы возникшей проблемы.
Часто в мужском организме находится скрытая инфекция, которую очень трудно определить обычными методами исследования, например, с помощью анализа крови. Человек может и не догадываться, какие именно симптомы могут быть при таких заболеваниях, и обращается к врачу только в случае сильного обострения проблемы. Поэтому урологи часто берут и проверяют мазок у мужчин на скрытые инфекции. Своевременное выявление вредных микроорганизмов всегда способствует предотвращению их дальнейшего развития и нейтрализует все негативные факторы, которые связаны с этим процессом. Врач может назначить взятие мазка из уретры в таких случаях:
- анализ с целью профилактики;
- в случае инфекционных заболеваний;
- при наличии воспалительных процессов в системе мужских половых органов;
- для проверки выделения, которое характеризуется неприятным запахом;
- при сильном зуде;
- с целью выяснения причины дискомфорта в уретре.
Выявление болезней при взятии мазка
С помощью этого исследования врач-уролог может определить, какие медикаментозные средства необходимы для лечения конкретного типа инфекционного заболевания. Такие анализы позволяют выявить множество негативных микроорганизмов в уретре мужчины. Впоследствии специалистам удается предотвратить их распространение и проявление различных осложнений. Даже скрытые инфекции у мужчин, когда они сдают мазок на проверку, поддаются исследованию. Этот материал очень тщательно проверяется с помощью микроскопа и составляется общая характеристика микрофлоры в уретре. Анализ дает возможность врачу выявить следующие факторы:
- болезнетворные бактерии и микроорганизмы — их количество и тип;
- содержание эритроцитов и лейкоцитов;
- состав и характеристика микрофлоры;
- анализ различных грибков и вредоносных бактерий.
С помощью взятия мазка у мужчин можно выявить множество различных заболеваний, очаг которых находится в уретре. Однако бывают случаи, когда врач не может полностью исследовать с помощью микроскопа, например, скрытые инфекции. В такой ситуации рекомендуется применить дополнительный культуральный анализ. Его суть заключается в количественном определении микроорганизмов, которые обитают в мужской уретре. Также применяется метод полимеразной цепной реакции, на основании которого можно выявить много различных ЗППП у мужчин, то есть заболеваний, передающихся половым путем. Анализ мазка из уретры у мужчин применяется для выявления следующих болезней:
- простатит;
- уретрит;
- гонорея;
- хламидиоз;
- уреаплазмоз;
- трихомониаз.
Процесс взятия мазка у мужчины
Процедура сбора материала из уретры для его последующей проверки осуществляется с помощью специальных средств и длится на протяжении 2-3 минут. Врач может извлечь мазок, используя небольшой тампон или зонд. Эти инструменты вводятся в мочеиспускательный канал мужчины и производится процедура взятия соскоба. Как правило, глубина такого ввода не превышает 4-5 см. В некоторых случаях процесс взятия соскоба может быть достаточно неприятным и даже болезненным.
После забора мазка пациенты часто жалуются на последующий дискомфорт и небольшое жжение в головке полового органа. Это считается нормальным процессом, который полностью проходит через некоторое время. Практика показывает, что во время взятия соскоба здоровому мужчине практически не бывает больно. Он может почувствовать только небольшой дискомфорт, который через короткое время исчезает. Если во время процедуры пациенту становится слишком больно, то это, как правило, свидетельствует о наличии в уретре сильного воспалительного процесса или инфекционного заболевания.
В некоторых случаях врач может брать соскоб с целью определения конкретного вида болезни. Например, он отдельно исследует только мазок на ЗППП или мазок на скрытые инфекции. Такой анализ требуется для того, чтобы специалист мог определить, какой способ лечения будет наиболее эффективным при возникновении конкретной проблемы. Перед процедурой забора мазка врач может произвести массаж предстательной железы или мочевыводящего канала. Делается это с целью получения большего количества материала, необходимого для последующего анализа.
Подготовка к процедуре
Для максимальной информативности результатов анализа специалисты рекомендуют мужчинам заранее подготовиться к процессу взятия мазка из уретры. В первую очередь следует прекратить прием антибиотических средств за 1 неделю до процедуры. Обязательно нужно отказаться от употребления любых алкогольных напитков за день до процесса взятия соскоб. Чтобы сдать этот анализ и впоследствии получить максимально информативные результаты, мужчинам рекомендуется не вступать в половые отношения 6-7 часов до начала процедуры. Желательно не посещать туалет за 2-3 часа до анализа.
Процесс гигиены половых органов должен быть проведен за день до обследования, например, вечером. Не рекомендуется заниматься процедурой непосредственно перед взятием мазка. Каждый пациент, которому врач назначил вышеуказанный вид анализа, обязательно должен учитывать все эти принципы правильной подготовки. В противном случае специалисту будет намного труднее взять мазок и диагностировать скрытые инфекции или ЗППП у мужчин. От результатов анализа будет напрямую зависеть методика дальнейшего лечения и при недостаточной информативности необходимо делать повторное исследование. В такой ситуации пациент может начать курс терапии с опозданием, что может привести к возникновению различных осложнений.
Результаты анализов
После прохождения процедуры по взятию мазка из мужской уретры специалист передает изъятый материал в лабораторию. Здесь с помощью микроскопа и при необходимости других дополнительных средств будет обследована микрофлора и сформулирован результат проверки. Если в мазке были выявлены какие-то инфекции, мужчине назначается соответствующий курс лечения.
Но даже при хороших результатах этого анализа в организме может присутствовать скрытая инфекция, которую с первого раза не всегда получается выявить. Качество вышеуказанной процедуры во многом зависит от человеческого фактора. Если специалист окажется не очень внимательным, то попросту может не заметить наличия каких-то микроорганизмов. Однако на практике такие случаи происходят очень редко.
Бывают ситуации, когда врач обнаруживает дрожжи в мазке мужчины. Этот факт указывает на наличие у пациента кандидоза, или молочницы. Такое заболевание в основном характерно для женского организма, но в некоторых случаях достаточно остро проявляется у представителей сильного пола.
Выявленные дрожжи в мазке являются только одним из первичных признаков вышеуказанной проблемы.
При таком заболевании у мужчины могут сильно покраснеть половые органы, а на их поверхности появляется налет и отечность. Еще одним сопутствующим фактором заболевания является сильная головная боль и дискомфорт при мочеиспускании. После диагностирования этой проблемы специалист должен определить, какие препараты будут более эффективными при такой болезни, и назначить курс дальнейшего лечения. На сегодняшний день для устранения симптомов молочницы у мужчин существует достаточное количество медикаментозных средств.
Некоторые важные моменты
Процедура взятия мазка считается одним из недорогостоящих и достаточно качественных методов исследования микрофлоры уретры на скрытые инфекции или ЗППП у мужчин. Как правило, после прохождения этой процедуры пациент не должен ограничиваться никакими специальными рекомендациями только в том случае, если результат анализа окажется негативным.
https://www.youtube.com/watch??v=GMHInOzHdyY
При обнаружении вредных микроорганизмов в уретре мужчины врач в первую очередь должен выяснить, какие сопутствующие симптомы возникают при таком заболевании. После этого пациенту назначается соответствующий тип лечения с целью максимально качественного устранения проблемы.
При необходимости мужчины могут сдавать мазок несколько раз. Врач, как правило, берет повторный анализ у пациента с целью более точно выяснить, какие из микроорганизмов поддаются назначенной методике лечения. Количество обследований на взятие мазка определяет сам специалист. Здесь все зависит от типа заболевания и длительности периода терапии. Для здорового пациента вышеуказанная процедура не должна стать болезненной. Последствием взятия мазка может быть небольшой дискомфорт и жжение в области головки пениса, которые сами исчезают через некоторое время.
https://www.youtube.com/watch??v=VY0OVRSaEZ8
Однако если через 2-3 дня после сдачи анализа у мужчины появится гнойное выделение из мочевыводящего канала желто-зеленого цвета, сопровождающееся сильной болью, необходимо сразу же обратиться к лечащему врачу. В данном случае категорически не рекомендуется заниматься самолечением. Это может привести к негативным последствиям и спровоцировать появление серьезных осложнений. После дополнительного обследования специалист сам должен определить, каким образом устранить возникшую проблему.
Больно ли брать мазок у мужчин
Одним из методов современной лабораторной диагностики является взятие мазка. Такую процедуру проводят мужчинам, чтобы установить наличие воспалительных процессов непосредственно в мочеиспускательном канале. Следовательно, мазок на флору определяет, каков состав микрофлоры и уровень ее патогенности. По результатам такого обследования идентифицируют микроорганизмы, которые провоцируют возникновение инфекций.
Особенности процедуры
Чтобы результат мазка был правильным, мужчине нужно подготовиться к этой процедуре. Вообще взятие мазка порой пугает представителей сильного пола. Они полагают, что такая процедура крайне болезненна. В действительности если воспалительный процесс присутствует в уретре, то мазок доставит боль. Но болезненность такой процедуры зависит от навыков соответственного специалиста. Если не соблюдать условий подготовки к мазку, то возможны недостоверные показатели этой манипуляции.
Первым делом мужчине нужно на два дня отказаться от половых контактов. Гигиенические процедуры следует провести в вечернее время, накануне сдачи анализа. С утра гигиена полового органа не нужна. За два часа до сдачи мазка нельзя мочиться. За четырнадцать суток до процедуры нужно прекратить прием любых медикаментов. Если необходимо применять некоторые препараты на постоянной основе, то этот нюанс нужно обсудить с врачом. Возможно, специалист назначит временный аналог, не воздействующий на результаты мазка.
Необходимость процедуры
В настоящее время в урологии применяют множество видов диагностики. Но одной из самых легкодоступных и недорогих форм анализа признан именно мазок из уретры. Суть процедуры состоит в лабораторном изучении тканей, взятых из мочеиспускательного канала. Мазок — это ценное диагностическое мероприятие, которое позволяет быстро выявить, проанализировать ряд недугов. С помощью такого материала специалисты проверяют состав, а также качество микрофлоры в уретре.
В мужском организме нередко присутствуют скрытые инфекции. Их сложно определить через анализ крови или другие распространенные методики исследования. Нередко мужчины даже не догадываются, какие симптомы могут быть при определенных недугах. В итоге они обращаются в медучреждение лишь при сильном обострении проблемы. Поэтому современные урологи все чаще проверяют мужчин с помощью мазка из уретры, чтобы выявить скрытые инфекции.
- с профилактической целью;
- при инфекционных недугах;
- при наличии сильного зуда;
- чтобы выяснить причины дискомфорта в мочеиспускательном канале;
- при наличии воспаления в мочеполовой системе мужчины;
- чтобы проверить выделения, имеющие неприятный запах.
Даже скрытые инфекции при мазке из уретры поддаются обследованию. Такой материал тщательно проверяют микроскопом. Затем специалист составляет общую характеристику микрофлоры в мочеиспускательном канале. Анализ даст возможность выявить количество и тип болезнетворных бактерий, содержание лейкоцитов и эритроцитов, характеристику и состав микрофлоры, провести анализ вредоносных бактерий и различных грибков.
Взятие мазка дает возможность выявить целый перечень заболеваний, очаг которых локализуется непосредственно в уретре. Но бывают случаи, когда специалисту не удается полностью исследовать мазок через микроскоп. Это актуально при наличии скрытых инфекции. Тогда рекомендуется помимо мазка из уретры сдать культуральный анализ, представляющий собой количественное определение микроорганизмов, обитающих в мужском мочеиспускательном канале. Кроме того, применяется методика полимеразной цепной реакции. Она позволяет определить различные заболевания, передающиеся в процессе интимной близости. Анализ мазка из мочеиспускательного канала актуален при подозрении на простатит, уретрит, хламидиоз, гонорею, трихомониаз, уреаплазмоз.
Больно ли брать мазок у мужчин: особенность и необходимость процедуры
Одной из недорогих и легкодоступных форм анализа в урологии является взятие мазка у мужчин. Суть данной процедуры заключается в лабораторном изучении тканей, которые при помощи специальной методики изымаются из уретры. Мазок является ценным средством, что позволяет оперативно выявить и проанализировать множество видов заболеваний. Также с помощью этого материала, который выбирается из мужской уретры, специалисты могут проверить состав и качество микрофлоры в мочевыводящих канале. На практике бывают случаи, когда для диагностирования определенных заболеваний нужно только лабораторный анализ мазка.
Особенность процедуры и ее необходимость
В очень многих ситуациях мужчины обязаны обращаться за помощью к специалисту по урологии. Для полноценного и качественного исследования им необходимо сдать мазок из уретры. Такой специальный анализ дает возможность врачу определить, какие типы микроорганизмов и в каких количествах находятся в мочевыделительной системы мужчины. С помощью взятия мазка специалист в очень короткое время сможет выяснить наличие инфекционного очага в этой области мужского полового органа и, соответственно, назначить определенный курс лечения. Практически все врачи перед тем, как берут материал для анализа, всегда консультируют пациента и выясняют основные симптомы возникшей проблемы.
- анализ с целью профилактики;
- в случае инфекционных заболеваний;
- при наличии воспалительных процессов в системе мужских половых органов;
- для проверки выделения, которое характеризуется неприятным запахом;
- при сильном зуде;
- с целью выяснения причины дискомфорта в уретре.
Выявление болезней при взятии мазка
С помощью этого исследования врач-уролог может определить, какие медикаментозные средства необходимые для лечения конкретного типа инфекционного заболевания. Такие анализы позволяют обнаружить множество негативных микроорганизмов в уретре мужчины. Впоследствии специалистам удается предотвратить их распространение и проявление различных осложнений. даже скрытые инфекции у мужчин, когда они сдают мазок на проверку, поддаются изучению. Этот материал очень тщательно проверяется с помощью микроскопа и состоит общая характеристика микрофлоры в уретре. Анализ дает возможность врачу выявить следующие факторы:
- болезнетворные бактерии и микроорганизмы — их количество и тип;
- содержание эритроцитов и лейкоцитов;
- состав и характеристика микрофлоры;
- анализ различных грибков и вредных бактерий.
С помощью взятия мазка у мужчин можно выявить множество различных заболеваний, очаг которых находится в уретре. Однако бывают случаи, когда врач не может полностью исследовать с помощью микроскопа, например, скрытые инфекции. В такой ситуации рекомендуется применить дополнительный культуральный анализ. Его суть заключается в количественном определении микроорганизмов, которые живут в мужской уретре. Также применяется метод полимеразной цепной реакции, на основании которого можно выявить много различных ЗППП у мужчин, то есть заболеваний, передающихся половым путем. Анализ мазка из уретры у мужчин применяется для выявления следующих болезней:
- простатит;
- уретрит;
- гонорея;
- хламидиоз;
- уреаплазмоз;
- трихомониаз.
Процесс взятия мазка у мужчины
Процедура сбора материала из уретры для его дальнейшей проверки осуществляется с помощью специальных средств и продолжается в течение 2-3 минут. Врач может получить мазок, используя небольшой тампон или зонд. Эти инструменты вводятся в мочеиспускательный канал мужчины и проводится процедура взятия соскоба. Как правило, глубина такого ввода не превышает 4-5 см. В некоторых случаях процесс взятия соскоба может быть достаточно неприятным и даже болезненным.
В некоторых случаях врач может брать соскоб с целью определения конкретного вида болезни. Например, он отдельно исследует только мазок на ИППП или мазок на скрытые инфекции. Такой анализ нужно для того, чтобы специалист мог определить, какой способ лечения будет наиболее эффективным при возникновении конкретной проблемы. Перед процедурой забора мазка врач может сделать массаж предстательной железы или мочеиспускательного канала. Делается это с целью получения большего количества материала, необходимого для дальнейшего анализа.
Подготовка к процедуре
Процесс гигиены половых органов должен быть проведен за день до обследования, например, вечером. Не рекомендуется заниматься процедурой непосредственно перед взятием мазка. Каждый пациент, которому врач назначил вышеуказанный вид анализа, обязательно должен учитывать все эти принципы правильной подготовки. В противном случае специалисту будет гораздо труднее взять мазок и диагностировать скрытые инфекции или ЗППП у мужчин. От результатов анализа будет напрямую зависеть методика дальнейшего лечения и при недостаточной информативности необходимо делать повторное исследование. В такой ситуации пациент может начать курс терапии с опозданием, что может привести к возникновению различных осложнений.
Результаты анализов
После прохождения процедуры по взятию мазка из мужской уретры специалист передает изъятый материал в лабораторию. Здесь с помощью микроскопа и при необходимости других дополнительных средств будет обследована микрофлора и сформулирован результат проверки. Если в мазке были обнаружены какие-то инфекции, мужчине назначается соответствующий курс лечения.
Но даже при хороших результатах этого анализа в организме может присутствовать скрытая инфекция, которую с первого раза не всегда получается обнаружить. Качество вышеуказанной процедуры во многом зависит от человеческого фактора. Если специалист окажется не очень внимательным, то просто может не заметить наличия каких-либо микроорганизмов. Однако на практике такие случаи происходят очень редко.
Бывают ситуации, когда врач обнаруживает дрожжи в мазке мужчины. Этот факт указывает на наличие у пациента кандидоза, или молочницы. Такое заболевание в основном характерно для женского организма, но в некоторых случаях весьма остро проявляется у представителей сильного пола.
Обнаружены дрожжи в мазке является только одним из первичных признаков вышеуказанной проблемы.
При таком заболевании у мужчины могут сильно покраснеть половые органы, а на их поверхности появляется налет и отечность. Еще одним сопутствующим фактором заболевания является сильная головная боль и дискомфорт при мочеиспускании. После диагностирования этой проблемы специалист должен определить, какие препараты будут более эффективны при такой болезни и назначить курс последующего лечения. На сегодняшний день для устранения симптомов молочницы у мужчин существует достаточное количество медикаментозных средств.
Некоторые важные моменты
Процедура взятия мазка считается одним из недорогих и достаточно качественных методов исследования микрофлоры уретры на скрытые инфекции или ЗППП у мужчин. Как правило, после прохождения этой процедуры пациент не должен ограничиваться никакими специальными рекомендациями только в том случае, если результат анализа окажется отрицательным.
При выявлении вредных микроорганизмов в уретре мужчины врач в первую очередь должен выяснить, какие сопутствующие симптомы возникают при таком заболевании. После этого пациенту назначается соответствующий тип лечения с целью максимально качественного устранения проблемы.
При необходимости мужчины могут сдавать мазок несколько раз. Врач, как правило, берет повторный анализ у пациента с целью более точно выяснить, какие из микроорганизмов подвергаются назначенной методике лечения. Количество обследований на взятие мазка определяет сам специалист. Здесь все зависит от типа заболевания и продолжительности периода терапии. Для здорового пациента вышеуказанная процедура не должна быть болезненной. Следствием взятия мазка может быть небольшой дискомфорт и жжение в области головки пениса, которые сами исчезают через некоторое время.
Однако если через 2-3 дня после сдачи анализа у мужа появится гнойное выделение из мочеиспускательного канала желто-зеленого цвета, что сопровождается сильной болью, необходимо сразу же обратиться к врачу. В данном случае категорически не рекомендуется заниматься самолечением. Это может привести к негативным последствиям и спровоцировать появление серьезных осложнений. После дополнительного обследования специалист сам должен определить, каким образом устранить проблему.